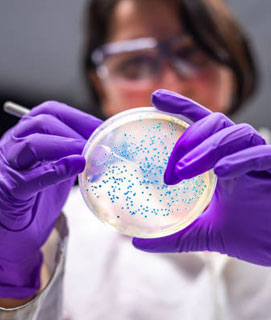
PATHOLOGY

About KLE JGMMMC

The Jagadguru Gangadhar Mahaswamigalu Moorsavirmath Medical College (JGMMMC) of KLE Academy of Higher Education & Research (Deemed-to-be-University) being established at Gabbur, Hubballi. It is the Second Medical College of KAHER. The Karnataka Lingayat Education (KLE) Society, the sponsoring society of KAHER has a rich history of imparting quality education in this Norther part of Karnataka, Southern part of Maharashtra and even in Delhi.
Courses Offered

MBBS
Testimonials from students of 1st Batch
KLE Suchirayu Teaching Hospital
of JGMM MC
The hospital has 330 beds with all the departments like Medicine, Surgery, Pediatrics, Obst. Gynecology, Orthopedics, Anesthesiology, Dermatology, Pulmonary Medicine, ENT, Ophthalmology, Psychiatry, Radio-diagnosis Dentistry with well-equipped OTs, ICUs to cater all type of Emergency Cases.
Departments
The College has fully equipped pre-clinical departments like Anatomy, Physiology and Biochemistry along with para-clinical departments like Pathology, Forensic Medicine, Pharamacology, Microbiology and Community Medicine with State-of-the-art infrastructure and facilities.